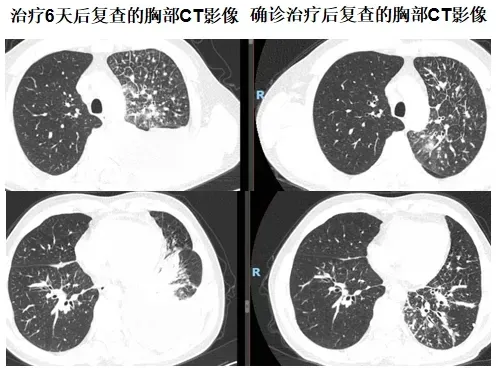
IMG_258

近日,延安市中医医院(北京大学第三医院延安分院)肺病科成功诊治一例肺部感染合并肺部肿瘤患者,为患者的健康带来新希望,彰显了肺病科在疑难病症诊疗上的专业素养与团队协作精神。

患者为52岁男性,两个月前无明显诱因出现咳嗽、咳黄痰且痰液粘稠难咳,伴有低热。先后辗转于多家医院寻求救治,均被诊断为社区获得性肺炎,并接受了相应的抗炎、化痰、止咳等常规治疗,然而症状未见缓解,病情逐渐加重,胸闷、气短等不适症状严重影响患者的日常生活。听闻延安市中医医院肺病科在肺部疑难病症诊治方面有丰富经验,遂前来就诊。入院后,胸部CT显示:左肺及右肺上叶存在感染性病变,左肺较重,左侧胸腔少量积液,纵隔及左肺门多发肿大淋巴结,左肺下叶外基底段病灶存疑;同时扫及肝内囊性灶。门诊初步诊断为“社区获得性肺炎”。
经过六天的规范治疗,患者胸闷、气短症状愈发明显。见此情形,延安市中医医院肺病科专家团队紧急为患者复查胸部CT。对比入院时的影像资料,发现左肺感染进展,胸腔积液增多,右肺下叶新发感染。肺病科的谢加利主任和艾克东副主任临危不乱,凭借多年积累的丰富临床经验和敏锐的专业洞察力,对患者的病情展开深入细致的分析。他们在仔细研读CT影像时,敏锐地捕捉到一系列异常细节:患者胸水单侧且发展迅速、左肺淋巴管增粗、胸水呈淡血性,结合胸水细菌培养+药敏结果(肺炎克雷伯菌感染)及结合药敏抗炎不佳的情况,考虑肺炎合并肿瘤可能性大。

时间紧迫,分秒必争。当务之急便是获取肺部病变组织的病理结果,才能为后续的治疗指明方向。与患者家属充分沟通后,为患者实施了CT引导下经皮左肺病变穿刺活检术,手术团队凭借精湛娴熟的技术,成功获取了病变组织样本。经过严谨细致的病理检测,最终确诊为左肺腺癌。在全体医护人员的悉心照料与专业治疗下,患者病情迅速得到控制并好转,患者的脸上重新绽放出久违的笑容。
该患者的成功诊治,得益于延安市中医医院肺病科医疗团队的精湛医术、无畏勇气与不懈坚持,他们以实际行动诠释了“以病人为中心,以优质服务为核心”的崇高服务理念。未来,延安市中医医院将继续秉持这一理念,以高尚的医德、精湛的医术、优质的服务、人性化的管理砥砺前行,为更多患者的健康保驾护航。(艾克东 陈怡园)
责编:杜鹏飞
编辑:刘静